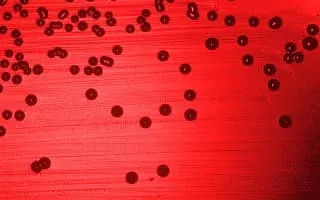

Haemophilus
| Use attributes for filter ! | |
| Scientific name | Haemophilus |
|---|---|
| Higher classification | Pasteurellaceae |
| Phylum | Proteobacteria |
| Order | Pasteurellaceae |
| Rank | Genus |
| Class | Gammaproteobacteria |
| Lower classifications | Haemophilus influenzae |
| Date of Reg. | |
| Date of Upd. | |
| ID | 2180672 |
About Haemophilus
Haemophilus is a genus of Gram-negative, pleomorphic, coccobacilli bacteria belonging to the family Pasteurellaceae. While Haemophilus bacteria are typically small coccobacilli, they are categorized as pleomorphic bacteria because of the wide range of shapes they occasionally assume.